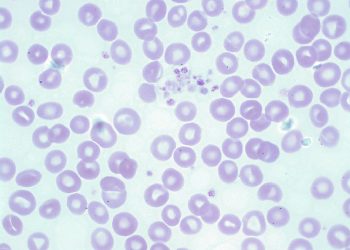

医保价格|艾曲波帕|艾曲泊帕乙醇胺片多少钱一盒一瓶,国产老挝孟加拉印度艾曲波帕代购哪里买,血小板减少艾曲波帕功效与作用效果,规格剂量用法说明书
艾曲波帕(Eltrombopag、艾曲泊帕乙醇胺片)是一种非肽类的血小板生成素受体激动剂,可以用于治疗既往对糖皮质激素、免疫球蛋白等治疗反应不佳的慢性免疫性(特发性)血小板减少症(ITP)。作为全球首个ITP口服方案,艾曲波帕更便捷,患者依从性强,艾曲波帕通过刺激血小板的骨髓巨核细胞增生和分化,起到升高血小板的作用,能明显降低出血率,减少输血频次。艾曲泊帕在国内于2018年1月4日获批上市,很多患者关注艾曲泊帕乙醇胺片/艾曲波帕医保价格多少钱一盒一瓶?目前艾曲波帕已经在国内上市并纳入我国乙类医保报销项目,国产艾曲泊帕还未上市,国内上市的艾曲波帕是进口原研药,进口艾曲泊帕医保后自费价格约为3140-5980元一盒,一盒规格是(25mg/28片)各个地区报销价格可能有区别。对比下来,印度艾曲波帕价格更低,并且印度艾曲波帕效果、用法均与进口版一致。分享印度艾曲波帕多少钱一盒,印度艾曲波帕多少钱一瓶?最新印度艾曲泊帕价格范围约1270~2200元左右,其中购买规格为(25mg/28片)一盒印度艾曲泊帕乙醇胺片价格是1270元起,另一种规格为(50mg/28片)一盒印度艾曲泊帕乙醇胺片价格是2200元左右,那么印度艾曲波帕代购,印度艾曲波帕哪里买?
第①印度当地购买:比如亲自前往印度本地购买印度艾曲泊帕;
第②另外,国内也有一些专业的海外医疗代购机构,如维耐国际医疗【微信:wndg91】等,通常具有长期的海外医疗直邮代购渠道,渠道正规专业。

血小板减少症印度艾曲波帕功效与作用效果
艾曲泊帕乙醇胺是一种口服特效药,用于提升血小板计数。血小板不足可能导致皮下出血或内出血,危及生命。首先,艾曲波帕能够刺激血小板的骨髓巨核细胞增生和分化,从而促进血小板的生成。这有助于增加患者体内的血小板数量,从而降低出血风险。
其次,艾曲波帕在治疗血小板减少症方面显示出良好的疗效。临床研究表明,艾曲波帕可以显著提高患者的血小板计数,并减少出血事件的发生。此外,艾曲波帕还可以改善患者的生活质量,减轻因血小板减少症引起的疲劳、乏力等症状。
临床数据
慢性特发性血小板减少性紫癜:艾曲泊帕在临床试验中,相对于安慰剂,显著提高了患者的血小板计数。在成人患者中,血小板大于50×10^9/L的比例分别为59%和70%,远高于安慰剂的16%和11%。对于未成年患者,效果同样显著。重度再生障碍性贫血:艾曲泊帕联合其他方案(如抗胸腺球蛋白和环孢素)在临床试验中,中位血液学总应答时间达到24.3个月,总应答率高达79%。可见艾曲泊帕乙醇胺片对多种血小板减少性疾病有显著疗效!
艾曲泊帕、海曲泊帕与阿伐曲泊帕如何选择:
艾曲泊帕、海曲泊帕与阿伐曲泊帕都属于非肽类促血小板生成素受体激动剂,但是在研发背景、国产属性以及适应症上存在一定的差异。
首先,艾曲波帕作为首个ITP(免疫性血小板减少症)的口服药物,为后来的非肽类促血小板生成素受体激动剂的发展奠定了基础。海曲泊帕则在艾曲泊帕的基础上研发,是国产药,目前在其他国家没有。
阿伐曲泊帕与艾曲泊帕乙醇胺片的主要区别在于其适应症的差异。马来酸阿伐曲泊帕片主要用于即将接受诊断性操作或手术的慢性肝病相关的成年血小板减少症患者。但需注意,对于慢性肝病患者来说,阿伐曲泊帕并不适用于恢复正常的血小板计数。相比之下,艾曲泊帕乙醇胺片则用于对糖皮质激素、免疫球蛋白等传统治疗方法效果不佳的成人慢性免疫性(特发性)血小板减少症(ITP)患者。它能有效增加血小板水平,减少或防止出血,特别适用于因血小板减少和临床条件导致的出血风险增加的ITP患者。
- 印度艾曲波帕包装规格:25mg和50mg,均为28片装每盒。
- 推荐剂量:成人患者的起始剂量为每日1次,每次25mg,用温水正片吞服,不要咀嚼弄碎。
- 用法:艾曲波帕应在空腹时服用,即在餐前1小时或餐后2小时服用。这是因为食物中的某些成分可能会影响艾曲波帕的吸收。同时,患者在服用艾曲波帕期间应避免与其他方案、食物或多价阳离子(如铁、钙、铝、镁、硒和锌)添加剂同时使用,以免发生相互作用。如果需要同时使用这些方案或添加剂,应间隔至少4小时。
- 逐步增加剂量:基于患者的反应和血小板计数情况,每2到4周可以逐渐增加剂量,每次增量范围在25mg至50mg之间,但最大剂量不可超过75mg。
- 监测血小板计数:对于成人患者,治疗期间应持续监测血小板计数,确保其维持在50000/微升以上,以有效降低出血的风险。
- 低于标准值的调整:如果在至少2周的治疗后,血小板计数仍低于50000/微升,应考虑以25mg为单位,每日增加剂量,并至少每周检测一次血小板计数。等待两周后,根据检测结果决定是否需要继续调整剂量。
- 高于标准值的减量:当血小板计数达到150000-250000/微升时,可以考虑以25mg为单位,逐日减少用量或降低使用频率。同样,每周检测一次血小板计数,并等待两周后根据检测结果决定是否需要继续减量。
- 停用与重启:若血小板计数超过250000/微升,建议暂停使用艾曲泊帕,并每周检测两次血小板计数。若计数降至100000/微升或以下,可以考虑重新启动治疗,但每日剂量应减少25mg。
- 肝硬化患者的特殊考虑:对于肝硬化患者,若医生评估认为可以使用艾曲泊帕,治疗应以25mg的剂量隔日服用一次开始。在增加剂量之前,需等待三周的时间。
注意事项:
- 肝功能监测:由于艾曲波帕可能影响肝功能,因此在使用期间应定期监测肝功能指标,如转氨酶等。
- 出血风险:虽然艾曲波帕能够增加血小板计数并降低出血风险,但在使用期间仍需注意避免受伤或进行可能导致出血的活动。
- 相互作用:艾曲波帕可能与其他方案发生相互作用,因此在使用艾曲泊帕前应告知医生正在使用的其他方案。
- 孕妇及哺乳期妇女:孕妇及哺乳期妇女在使用艾曲波帕前应咨询医生,权衡利弊后决定是否使用。
印度艾曲波帕效果:印度艾曲泊帕效实案例
患者李女士,50岁,因长期患有慢性免疫性血小板减少性紫癜(ITP),血小板计数一直维持在较低水平,严重影响了她的日常生活。她之前尝试过多种治疗方法,包括糖皮质激素、免疫球蛋白以及脾切除等,但效果均不理想,血小板计数仍然难以稳定。
在医生的建议下,李女士开始尝试使用印度艾曲波帕进行治疗。在起始阶段,医生根据她的具体情况为她制定了个性化的治疗方案,包括合适的剂量和用法。李女士按照医生的建议,每天按时服用艾曲波帕,并定期进行血小板计数和其他相关指标的监测。经过几个月的治疗,李女士的血小板计数开始逐渐上升,并稳定在了一个较为理想的水平。她的出血症状也得到了明显的改善,不再频繁出现。同时,她的生活质量也得到了显著的提高,能够正常地参与日常生活和工作。

艾曲泊帕乙醇胺片多少钱一盒,国产艾曲波帕多少钱一盒,艾曲波帕28粒一盒价格,老挝艾曲波帕多少钱一盒,孟加拉艾曲波帕多少钱一盒,印度艾曲波帕多少钱一瓶:
- 国内进口艾曲泊帕价格:25mg*28片,5980元/盒
- 老挝艾曲波帕价格:25mg*28片,1000~2300元/盒
- 孟加拉艾曲波帕价格:25mg*28粒,1000~2300元/盒
- 印度艾曲波帕价格:25mg*28片,1270元/盒;50mg*28片 2200元/盒
对比结果:虽然老挝、孟加拉版艾曲波帕比印度艾曲波帕价格略微便宜,但是印度作为全球知名制药出口大国,无论从效果口碑还是质量管控方面,都是远超老挝孟加拉,印度艾曲波帕效果和原厂保持一致性,是目前性价比最高的选择。

老挝艾曲波帕哪里买,孟加拉艾曲波帕代购哪里买,印度艾曲波帕哪里买:
①前往印度购买:如果您有前往印度的机会,可以直接在印度的药店或医疗机构购买艾曲泊帕。
②通过专业医疗代购机构购买:在国内不出国,也可以通过专业的海外医疗代购机构,如维耐国际医疗【微信:wndg91】等,从印度知名药房直接邮寄包裹到家,印度维耐长期稳定地为国内患者对接印度药房,提供方便快捷的直邮服务,价格实惠,正品有保障!



